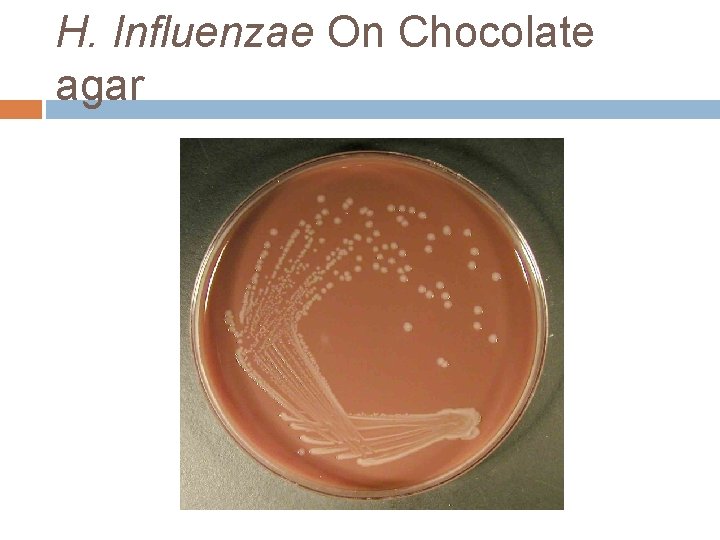
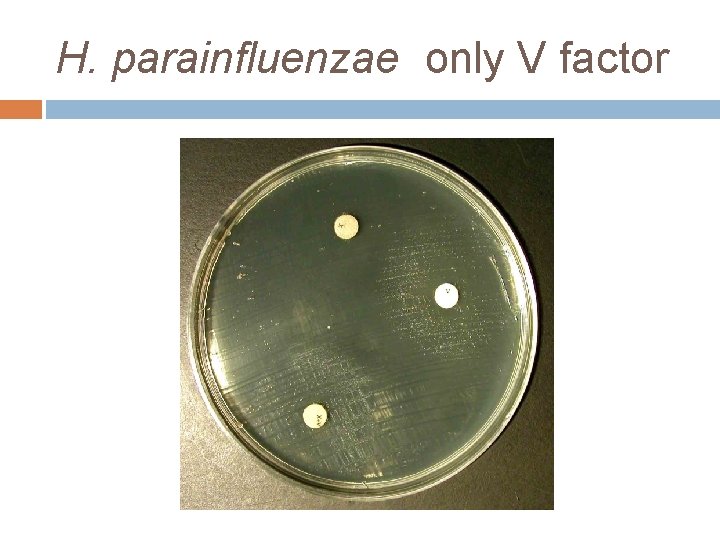

CEREBROSPINAL FLUID CSF CULTURE D M M Lab

CEREBROSPINAL FLUID (CSF) CULTURE D. M. M. Lab.

CSF culture § § § § Aim of the test Diagnosis of the bacteria or fungal meningitis by microscopic examination and culture with identification and susceptibility test of the isolated organism. Types of specimen CSF Criteria of specimen rejection Non sterile container and the general causes for rejection stated in the introduction as mislabeling, un-labeling, insufficient amount. Specimen more than 30 minutes.

Infection of CSF Common bacterial pathogen Haemophilus influenzae Salmonella (rare) Neisseria meningitidis Brucella (rare) Streptococcus pneumoniae Treponema pallidum (rare) Group A & B streptococci Listeria monocytogenes Gram negative bacilli Viruses Enteroviruses(coxsackieviruses Herpes simplex virus A and B, echoviruses) Mumps virus Arboviruses (togavirus, bugavirus and other) Parasite Free living amoebae Toxoplasma (rare) Toxoplasma gondii Strongyloides strecoralis Entamoeba histolytica Microbes that cause chronic meningitis M. tuberculosis Blastomyces dermatitides Cryptococcus neoformans Candida spp. Coccidoides immitis Nocardia Histoplasma capsulatum Actinomyces Note: CSF is a sterile body fluid and does not contain any commensals; however, care should be taken not to contaminate the specimen with skin normal flora during collection.

Pre specimen processing Specimen collection Who will collect the specimen Only physicians. Quantity of specimen Mini. 5 -10 ml of CSF is recommended for culture. Time relapse before processing the sample CSF is an emergency specimen and should be processed immediately. Storage Room Temperature, Do not refrigerate.

Specimen processing

Initial Processing Initial processing of CSF for bacterial and fungal detection includes centrifugation of all specimens greater than 1 m. L in volume for at least 15 minutes at 1500 x g. The supernatant is removed to a sterile tube, leaving approximately 0. 5 m. L of fluid in which to suspend the sediment before visual examination or culture. The supernatant can be used for to test for the presence of antigens or for chemistry evaluations. Note: if the specimen turbid it is not necessary to make the initial processing as mentioned above.

Staining of CSF After thoroughly mixing the sediment heaped drop is placed on the surface on a sterile slide. The sediment should never spread out on the slide surface, because this increases the difficulty of finding small numbers of microorganisms, the drop of sediment is allowed to air dry, and heated or methanol fixed and stained by gram stain, and another slide stained by Methylene blue in parallel.

India ink stain: the large polysaccharide capsule of cryptococcus neoformans allows these organisms to be visualized After mixing the CSF and ink to make a smooth suspension, a coverslip is applied to the drop and the preparation is examined under high power magnification for characteristics encapsulated yeast cells and by oil immersion.

Wet mount preparation Wet mount: amoebas are best observed by examining thoroughly mixed sediment as a wet preparation under phase contrast microscopy or light microscopy with the condenser closed slightly. Amoebas are recognized by typical slow, methodical movement in one direction by advancing pseudopodia.

Blind Culturing After vortexing the sediment and preparing smears Several drops of the sediment shoud be inoculated to each medium. Plates should be incubated at 37 o. C for at least 72 hours. The broth should be incubated in air for at least 5 days. These media will support the growth of almost all bacterial pathogens and several fungi.

Post specimen processing Interfering factors Patient on antibiotic therapy. Improper sample collection. Result reporting Results of the microscopy and all positive cultures of CSF are reported immediately to the treating physician. Turn around time Gram stain result is reported within 30 minutes of specimen receipt Positive Culture results = 3 - 5 days Negative Culture results = 2 -3 days

Additional information Total and differential white blood cell count is essential particularly in the differentiation of bacterial and non-bacterial meningitis. In bacterial meningitis the glucose level is usually low and the protein level is high, where in viral meningitis the glucose is within normal value and might increase slightly. Several antigen detection methods are available for the direct detection of the polysaccharide capsular antigen of H. influenzae, N. meningitidis, S. pneumoniae and Group B streptococci in CSF which showed specificity and sensitivity of about 90 -97%. Direct detection of Cryptococcus antigen in CSF is also available which replaced India ink in many laboratories. The routine culture for CSF does not include all organisms mentioned in the above table.
H. Influenzae On Chocolate agar

X and V Factor test Members of the genus haemophilus require accessory growth factor in vitro Some haemophilus spp. X factor (hemin) alone, V factor (NAD) alone or acombination of both. Method I. Make avery light suspension ( 0. 5 Mac. Farland )of the organism in sterile saline. II. Dip a sterile swab in to the organism suspension. Roll the swab over the entire surfase of MH agar palte III. Place X, V, and XV factors disks on the agar surface. IV. Incubate overnight. Expected results: growth around the XV disks only shows required for both factors. ( H. influenzae ) growth around the XV, X and no growth around the V disk shows required only for X factor. ( H. ducreyi ) growth around the XV, V and no growth around the X disk shows required only for V factor. ( H. parainfluenzae ) Growth on all entire plate indicate no need for any of these factors. (H. aprophilus)
H. parainfluenzae only V factor

H. influenzae both V and X factors

Satellitism phenomenon Sheep blood agar contains hemin but not NAD, Several bacterial species including Staphylococcus aureus, produce NAD as a metabolic byproduct, therfore tiny colonies of Haemophilus spp. May be seen growing on blood agar very close to colonies that can produce V factor.
- Slides: 17